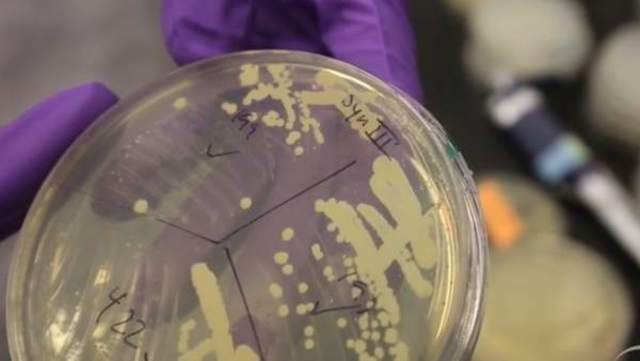
Cromosoma sintetico

-
El primer representante de la biología molecular fue Friedrich Miescher, logro aislar varias moléculas ricas en fosfato, a las cuales llamo nucleinas, a partir del núcleo de leucocitos.
-
Albrecht Kossel descifra la química de la
nucleina y de las proteínas que se
encuentran presentes en ella -
Richard Altman utilizo técnicas físico-químicas para estudiar las nucleinas, descubrió nuevas características y les dio el nombre de ácidos nucleicos
-
Theodor Boveri & Walter Sutton postulan el concepto de cromosoma como unidades básicas de la herencia, a partir de los ácidos nucleicos
-
Thomas Hunt Morgan logro confirmar que los cromosomas son los portadores de los genes
-
Phoebus Levene estudio la composición de los ácidos nucleicos y determino que se conforman de ácido fosfórico, una pentosa y bases nitrogenadas, propuso una estructura erronea
-
la comunidad científica mantiene la creencia de que los animales tenia solo ADN y las plantas ARN
-
Frederick Griffith llevo a cavo uno de los primeros experimentos que demostraría que las bacterias eran capaces de transferir información genética mediante un proceso llamado transformación.
-
Torbörn caspersson determino que el ADN es un polimero
-
A.N Belozerky extrajo ADN puro de una planta demostrando que las plantas tienen ambos tipos de nucleotidos
-
William Astbury estudio la difracción de rayos x en moléculas biológicas
-
Avery, Mcleod & McCarty se propusieron identificar el "principio transformante" de Griffith y realizan un experimento en el que lograron definir al ADN como la molecula responsable de la trasmicion de los caracteres hereditarios
-
Erwin Chargaff analizo los ácidos nucleicos, y concluyo que el numero de purinas no siempre es igual al numero de primidinas
-
Hershey & Chase estudiaron la genética de los bacteriófagos y realizaron un experimento para demostrar que el ADN es la base del material genético y no las proteínas
-
Pauling & Corey postulan la estrucctura de helice a y hoja plegada B en las proteinas
-
Es una una imagen tomada por Rosalind Franklin que captura la doble hélice del ADN, y fue lograda mediante la difracción de rayos X.
-
Watson & Crick descubren la estructura de doble hélice de ADN, bases nitrogenadas unidas por enlaces de hidrógeno y los armazones son azucares y fosfato
-
Sanger determina por primera ves la secuencia de la insulina
-
Ochoa & Gumberg-Manago descubren la polinucleotido fosforilasa y síntesis invitro de ARN
-
Meselson & Stahl realizan un experimento que confirma que la replicación de ADN es semiconservativa
-
Francis Crick propone la hipótesis del adaptador que establece que durante la biosíntesis de proteínas cada aminoácido se transporta al RNA molde por medio de una pequeña molécula de RNA adaptador, y que este adaptador es el que se fija al RNA mensajero.
-
Hoagland & Mahlon descubren que la molecula ARNt es un adaptador
-
Arthur Kornberg logra aislar la ADN polimeraza I
-
Hurwits co-descubrio la ARN polimeraza junto con Weiss
-
Kendrew & Peruts describen la estructura espacial de la hemoglobina y mioglobina
-
Jacob & Monod formularon el concepto de moléculas ARNm que codifican proteínas
-
Spiegelman introduce la técnica de hibridacion de ácidos nucleicos
-
Jacob, Monod & Lwoff postulan el modelo operon con el objetivo de controlar la exprecion genetica de las bacterias
-
Nirenberg, Ochoa, Khorona decifran el codigo genetico
-
Robert Holley logro definir la primera secuencia de ARN (ARNt de la valina)
-
David Phillips determina la estructura tridimencional de la lisozima
-
postulacion de la hipotesis de balanceo en la interaccion codon-anticodon que explica el reconocimiento de más de un codón por parte de un determinado ácido ribonucleico transferente
-
Ptashne & Gilbert reconocen el primer gen represor, Gen regulatorio cuyo producto es una proteína que controla la transcripción de un operon particular.
-
Robert Merrifield sintetizo la enzima ribonucleaza artificialmente
-
Arber, Nathans & Smith identifican endonucleasa de restriccion, son enzimas que cortan ADN. Cada enzima reconoce una o un número pequeño de secuencias blanco y corta el ADN en o cerca de esas secuencias.
-
Berg & Boyer son los primeros en crear una molécula de ADN recombinante, a partir de enzimas de restricción, primera clonacion exitosa
-
Cohen & Chang evidencian que el ADN recombinante puede ser replicado y mantenido en E-coli
-
primera patente en estados unidos de recombinacion genetica
-
Maxan & Gilbert logran desarrollar una tecnica para secuenciar acidos nucleicos de manera química
-
Sanger comienza el desarrollo de las técnicas de secuenciacion de ADN
-
Edwin Sauthern realiza un experimento con el metodo sauthern Blot para reconocer fragmentos de ADN por hibridacion
-
Boyer & Swanson fundan la primera empresa de inginieria genética llamada Genenthech incorporated
-
se logra obtener insulina humana a partir de una bacteria transformada
-
David Botstein descubre los RELP, una secuencia especifica de nucleotidos de ADN reconocidas y cortadas por enzimas de restrccion
-
Kary Mullis desarrolla la tecnica de reaccion en cadena de polimerasa (PCR) que permite clonar genes especificos
-
primer diagnostico prenatal de una enfermedad a partir de análisis de ADN
-
se crea el primer ratón transgenico "super ratón" al insertar el gen de la hormona de crecimiento de una rata en los óvulos fecundados de una hembra de ratón
-
creación de las primeras plantas trangenicas
-
se utiliza por primera vez la "huella genética" en una investigación judicial
-
Applied Biosystems crea el primer secuenciador automático, un sistema de electroforesis y detección de fluorescencia controlado por microprocesador que se utiliza para secuenciación automática
-
propuesta comercial para establecer la secuencia completa del genoma humano, proyecto genoma humano, comercialización del primer monoclonal de uso terapéutico
-
se crean los vectores de clonacion YACs, para insertar fragmentos de ADN grandes
-
se funda el NCBI en estados unidos, comienza la era de la bioenformatica
-
se funda La Organización HUGO(Organización del Genoma Humano), es una organización dentro del Proyecto de Genoma Humano,su objetivo es determinar el mapa de dicho genoma. en esa epoca se creia que el genoma tenia aproximadamente cincuenta o cien mil genes.
-
Craig Venter y su equipo describen los marcadores de secuencia expresada o EST que son pequeñas subsecuencias de una secuencia nucleotídica transcrita.
-
se hace posible la clonacion de embriones humanos
consigue por primera vez clonar embriones humanos,pero el experimento no consigue prosperar -
El primer organismo vivo que tuvo su genoma secuenciado fue la bacteria Haemophilus influenzae,
-
Se logra completar la secuencia de los genomas de la levadura y
de E. coli. -
clonación de la oveja Dolly, como primer mamífero en ser clonado de una célula adulta.
-
Se logra completar la secuencia del genoma de Caenerhabditis
elegans. -
se publica el primer borrador del genoma humano, proyecto genoma humano
-
se publica la secuencia del genoma de la Drosophila melanogaster, paso importante para comprender la genética humana
-
se publica el primer genoma de planta secuenciado: Arabidopsis thaliana
-
se publica primera versión culminada del genoma humano de los tres mil millones de pares de bases en el genoma humano.
-
Celera Genomics de Craig Venter hace publica la información sobre el genoma humano.
-
Se inicia el proyecto internacional HapMap (SNPs), creado para desarrollar un mapa de haplotipos del genoma humano
-
se logra hacer el primer trasplante de un genoma completo de una bacteria hacia otra bacteria
-
Shinya Yamanaka logra la transformación de una célula especializada en otro tipo celular diferente, basado en una combinacion de 4 genes
-
Se completa la primera fase del proyecto genoma humano.
-
se crea el primer modelo computacional de una célula.
-
Científicos de Celera Genomics fabrican cromosoma sintético a partir de célula de levadura.
-
tecnología que edita el ADN análogo al sistema CRISPR/Cas9, caracterizado en 2015 por el grupo de Feng Zhang‘s del Instituto Broad y MIT
Plan projects on a visual timeline
Map milestones, phases, deadlines, and key events in one place so the sequence is easier to see and share. Timetoast is a timeline maker for work, school, research, and stories.